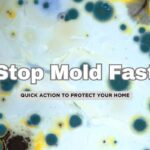
Top 10 Ways to Deal with Mold Post-Flood

Floods can be devastating, but one of the most dangerous and often overlooked risks is electricity. Water and electricity are a deadly combination, and even minor flooding can create serious hazards in your home. Knowing what to do before, during, and after a flood can help keep your family safe and prevent costly damage.
⚠️ Important Disclaimer:
Always prioritize safety when dealing with electrical hazards. If your home has experienced flooding, assume that all electrical systems and appliances may be compromised. Never enter a flooded area if water may be in contact with electrical outlets, appliances, or wiring. When in doubt, contact a licensed electrician before restoring power.
1️⃣ Turn Off Power Before Floodwaters Reach Your Home
If you have advance warning of a flood, shutting off power can prevent electrical fires, short circuits, and electrocution risks. Locate your main circuit breaker and turn off power to the entire house before water enters.
- If it’s safe, shut off power at the breaker panel or fuse box.
- If you have to stand in water to reach the breaker, do not attempt to turn it off—leave immediately and contact emergency services.
- Consider installing a main breaker shutoff switch in an easily accessible location for future emergencies.
2️⃣ Never Enter a Flooded Home Until Electrical Systems Are Inspected
Even if the floodwaters have receded, your home could still be a major electrocution hazard. Water can damage outlets, wiring, and appliances, leading to hidden dangers.
- If your home was flooded, do not turn the power back on until a qualified electrician has inspected your electrical system.
- Watch for downed power lines in your area before re-entering your property.
- If you hear buzzing sounds, see sparks, or smell burning plastic, stay out and call for professional help immediately.
3️⃣ Avoid Using Electrical Appliances or Devices in a Flooded Area
Even if power is still on during a flood, never use electrical appliances, outlets, or switches in or near standing water. Water conducts electricity, and even a small amount can turn your home into a serious electrocution hazard.
- Unplug appliances before floodwaters reach them, but only if it’s safe to do so.
- If your floors or walls are wet, avoid touching electrical outlets, cords, or switches—they could be energized.
- If a device or appliance has been submerged, do not turn it on. Floodwater can cause internal damage that may not be visible but could lead to electrical fires or shocks.
4️⃣ Watch for Electrical Hazards in Standing Water
After a flood, standing water inside or around your home could be electrically charged, even if power appears to be off. Floodwaters may have damaged underground or internal wiring, creating an unseen danger.
- Never assume floodwater is safe to walk through, especially in basements or near electrical equipment.
- If you must enter a flooded area, wear rubber boots and use a wooden stick to check for submerged objects before stepping in.
- If you see exposed wires, flickering lights, or hear buzzing sounds, leave immediately and contact a professional.
5️⃣ Be Cautious with Generators and Alternative Power Sources
Power outages often follow floods, leading many homeowners to rely on portable generators. While generators can be lifesaving, they can also create electrical and carbon monoxide hazards if not used correctly.
- Never operate a generator indoors or in an enclosed space—carbon monoxide buildup can be deadly.
- Keep generators at least 20 feet away from windows, doors, and vents.
- Plug appliances directly into the generator rather than using household wiring, unless you have a professionally installed transfer switch.
- Avoid backfeeding (plugging a generator into a wall outlet), as this can send electricity back into the grid and seriously injure utility workers.
6️⃣ Dispose of Water-Damaged Electrical Equipment Safely
Once floodwaters recede, never assume electrical devices or systems are still safe to use. Even if they appear dry, internal components may have suffered water damage, leading to short circuits, electrical fires, or electrocution risks.
- Any appliance, outlet, switch, or electrical panel that has been submerged should be inspected by a qualified electrician.
- Do not attempt to dry and reuse electrical devices such as toasters, microwaves, or power strips—they can remain dangerous even after drying out.
- Waterlogged extension cords, surge protectors, and power tools should be discarded and replaced.
7️⃣ Have a Licensed Electrician Inspect and Restore Power
Before restoring power to a flooded home, always get a professional inspection to ensure your electrical system is safe. Hidden damage in wiring or outlets can cause fires, shocks, or repeated power failures.
- Call a licensed electrician to inspect your breaker panel, outlets, and major appliances before turning the power back on.
- If you suspect electrical damage, contact your utility provider before reactivating service.
- Consider upgrading to flood-resistant electrical components, such as raised outlets and waterproof wiring, to reduce future risks.
8️⃣ Prepare for Future Floods with Electrical Safeguards
Flooding is unpredictable, but taking precautions now can protect your home’s electrical system in the future. A few simple upgrades can make a huge difference in preventing flood-related electrical damage.
- Raise outlets, switches, and breaker panels at least a foot above typical flood levels.
- Install ground fault circuit interrupters (GFCIs) in flood-prone areas to reduce the risk of electrocution.
- Consider battery backups or solar-powered emergency lighting in case of outages.
- Have a professional install a main shutoff switch in an accessible location so you can safely cut power before floodwaters reach your home.
Stay Safe and Stay Prepared
Floods bring many dangers, but electrical hazards are among the most life-threatening. Knowing how to handle electricity before, during, and after a flood can make all the difference in keeping your family and home safe.
If you’re in a flood-prone area, take steps now to safeguard your electrical system, and always consult a professional before restoring power after a flood. Your safety is worth the extra precaution.